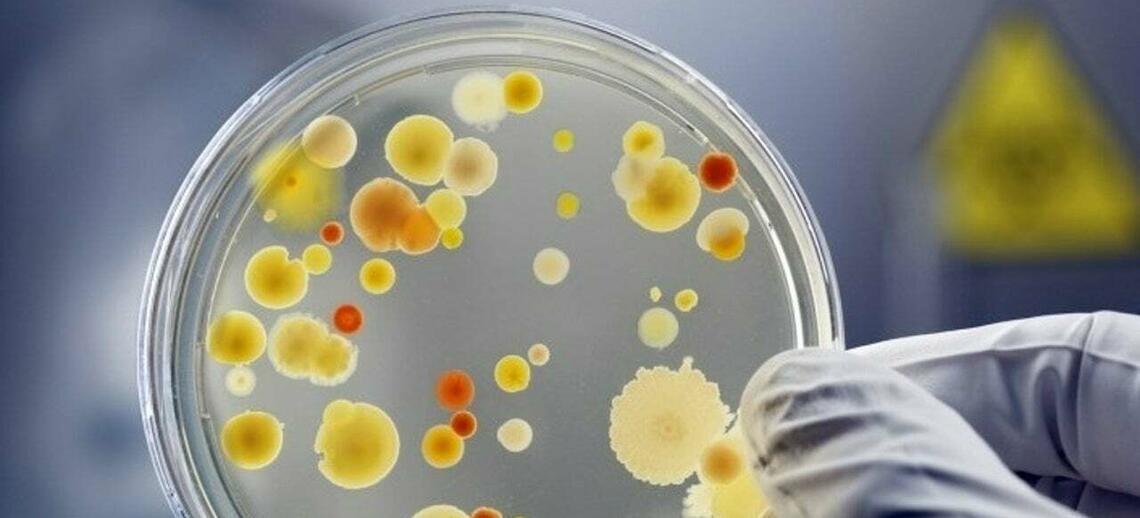
ohgr banner

Research Groups
UCVM supports a broad base of research excellence particularly in our Areas of Emphasis and strategic priority areas. We have established formal research groups to help develop our strategic priority areas and enhance their visibility. Each Group is shaped by the interests of their members. They bring together individuals with synergistic research expertise and enable collaborative research, knowledge translation and return to the community.
Cattle Health
The Cattle Health Research Group (CHRG) contributes to UCVM's mission of meeting the veterinary, animal and public health needs of Alberta through the creation and distribution of new knowledge through research, graduate veterinary education, and continuing education in animal health, disease and welfare.

Veterinary Clinical and Applied Research and Extension Group
Veterinary Clinical and Applied Research and Extension Group (VCARE) is a newly formed research group at UCVM that brings together clinical and basic researchers across various disciplines with the objective of fulfilling UCVM’s mission of advancing animal and human health and welfare.

Infection Biology
The Infection Biology research group was founded to enhance interactions between researchers working on infectious disease in the different UCVM departments and with other faculties.

One Health Research Group
The One Health Research Group at UCVM emphasizes the interconnectedness of human, animal, and environmental health. This multidisciplinary research initiative brings together experts from veterinary medicine, human medicine, environmental science, and public health to address complex health challenges. The group’s focus includes the prevention and control of zoonotic diseases, antimicrobial resistance, and the impact of environmental changes on both human and animal populations.
Reproduction and Regenerative Medicine
Research being conducted by the Reproduction and Regenerative Medicine Research Group brings together experts from veterinary and human medicine, stem cell biology, reproductive biology and bioengineering to promote a creative, multidisciplinary research environment with the capacity to translate scientific discovery into clinical reality.

Wildlife Health & Ecology
The Wildlife Health & Ecology group is a group with unique expertise in health of wildlife populations with a strong ecological and system-based approach.

Veterinary Education Research
The Veterinary Education Research Group (VERG) supports veterinary education by conducting relevant, practical educational research. Our members are internationally recognized experts and emerging researchers/educators that work across departments, specialties and with colleagues nationally and internationally.